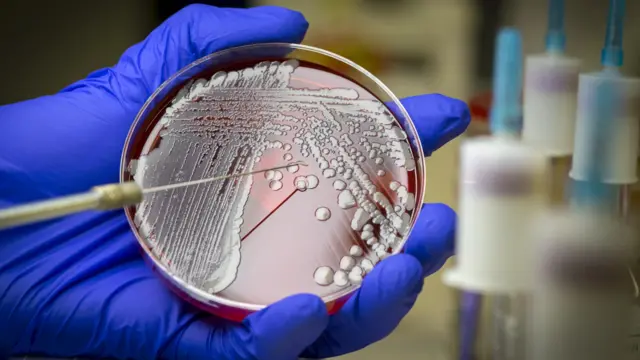
নমুনা পরীক্ষা।

অ্যান্টিবায়োটিক রেসিস্ট্যান্স কী, বুঝবেন কিভাবে

ছবির উৎস, Getty Images
বিশ্বব্যাপী স্বাস্থ্যখাতে নতুন এক অশনি সংকেত অ্যান্টিবায়োটিক রেসিস্ট্যান্স। অ্যান্টিবায়োটিক বা অ্যান্টিমাইক্রোবায়াল ড্রাগ এমন এক ধরণের ওষুধ যা ব্যাকটেরিয়া সংক্রমিত রোগের বিরুদ্ধে লড়াই করে। এই ওষুধ মানুষ বা পশুর দেহে প্রয়োগ করলে এটি শরীরের ব্যাকটেরিয়া মেরে ফেলে বা এর বংশবিস্তার রোধের মাধ্যমে রোগ নিরাময় করে। তাই ব্যাকটেরিয়ার আক্রমণ থেকে রক্ষা পেতে অ্যান্টিবায়োটিককে চিকিৎসা বিজ্ঞানের এক আশীর্বাদ বলা যায়।
কিন্তু সেই অ্যান্টিবায়োটিক সঠিক উপায়ে প্রয়োগ না করলে হিতে বিপরীত হতে পারে।
অ্যান্টিবায়োটিক রেসিস্ট্যান্স কী?
যদি কারও শরীরে ব্যাকটেরিয়ার সংক্রমণজনিত রোগ হয় এবং সেই রোগ নিরাময়ে কেউ যদি চিকিৎসকের পরামর্শমত সঠিক পরিমাণে এবং পর্যাপ্ত সময় ধরে অ্যান্টিবায়োটিক গ্রহণ না করেন তাহলে ব্যাকটেরিয়াগুলো পুরোপুরি ধ্বংস না হয়ে উল্টো আরও শক্তিশালী হয়ে উঠতে পারে।
তখন এই ব্যাকটেরিয়ার বিরুদ্ধে ওই অ্যান্টিবায়োটিক পরে আর কাজ করে না।
অ্যান্টিবায়োটিক প্রয়োগের পরেও ব্যাকটেরিয়ার এই টিকে থাকার ক্ষমতা অর্জনকে অ্যান্টিবায়োটিক রেজিস্ট্যান্স বলা হয়।
বাংলাদেশের বিভিন্ন হাসপাতালে সাধারণ রোগ নিয়ে চিকিৎসা নেয়া অনেক মানুষের মধ্যে এই অ্যান্টিবায়োটিক রেসিস্ট্যান্স দেখা দিয়েছে। এর ফলে রোগীর আগে যে অ্যান্টিবায়োটিকে রোগ সারতো, এখন আর সেটি কাজ করছে না। না হলে অত্যন্ত উচ্চ মাত্রার অ্যান্টিবায়োটিক দিতে হচ্ছে।
এভাবে মানুষের শরীরের রোগপ্রতিরোধ ক্ষমতা ক্রমে হ্রাস পাচ্ছে বলে জানান বঙ্গবন্ধু শেখ মুজিব মেডিকেল কলেজ হাসপাতালের মেডিসিন বিভাগের সহকারী অধ্যাপক তৌফিক আহমেদ।

ছবির উৎস, Getty Images
বিবিসি বাংলার সর্বশেষ খবর ও বিশ্লেষণ এখন সরাসরি আপনার ফোনে।
ফলো করুন, নোটিফিকেশন অন রাখুন
বিবিসি বাংলার সাথে থাকার জন্য ধন্যবাদ বিবিসি বাংলার হোয়াটসঅ্যাপ চ্যানেল
অ্যান্টিবায়োটিক রেসিস্ট্যান্সের কারণ কী?
বিশ্বে নতুন অ্যান্টিবায়োটিক তৈরি হতে যে সময় লাগে ওই সময়ের মধ্যেই কয়েকগুণ বেশি হারে বাড়ছে অ্যান্টিবায়োটিক রেসিস্ট্যান্স। যার ফলে অদূর ভবিষ্যতে সামান্য হাঁচি-কাশি-জ্বরেও মানুষের মৃত্যু-ঝুঁকি হতে পারে বলেও আশঙ্কা করা হচ্ছে। এ ব্যাপারে মি. আহমেদ বলেন, অ্যান্টিবায়োটিক রেসিস্ট্যান্সের সবচেয়ে বড় কারণ হল সাম্প্রতিক সময়ে অত্যধিক মাত্রায় অ্যান্টিবায়োটিকের ব্যবহার। অনেকেই জ্বর, মাথাব্যথা হলেই চিকিৎসকের ব্যবস্থাপত্র ছাড়াই অ্যান্টিবায়োটিক সেবন করেন। আবার অনেকে চিকিৎসকের পরামর্শে অ্যান্টিবায়োটিক নিলেও সেটার পূর্ণ কোর্স সম্পন্ন করেন না।
কয়েকটি খাবার পর ভালো বোধ করলেই ছেড়ে দেন। ফলে ওই ব্যাকটেরিয়ার বিরুদ্ধে অ্যান্টিবায়োটিকের আর কোন প্রভাব থাকে না বলে জানিয়েছেন মি. আহমেদ।
প্রকৃতি পরিবেশ থেকে হতে পারে অ্যান্টিবায়োটিক রেসিস্ট্যান্স
আবার অ্যান্টিবায়োটিক নিয়ম করে খাওয়া সত্ত্বেও শিশুরাও অ্যান্টিবায়োটিক রেসিস্ট্যান্সের শিকার হতে পারেন। এর কারণ প্রকৃতি-পরিবেশে অ্যান্টিবায়োটিকের বিস্তার। ইদানীং মাছ, হাঁস, মুরগি বা গরুকে অ্যান্টিবায়োটিক-যুক্ত খাবার দেয়া হয়। আবার শাকসবজির উৎপাদনেও ব্যবহার হয় অ্যান্টিবায়োটিক। ফলে এসব প্রাণীর কাঁচা মাংসের সংস্পর্শে এলে, আধা-সেদ্ধ অবস্থায় খেলে অ্যান্টিবায়োটিক রেসিস্ট্যান্স তৈরি হওয়ার আশঙ্কা থাকে, বলছেন মি. আহমেদ।

ছবির উৎস, Getty Images
অ্যান্টিবায়োটিক রেসিস্ট্যান্সের পরীক্ষা
কিন্তু কোন ব্যক্তি অ্যান্টিবায়োটিক রেসিস্ট্যান্ট কিনা সেটা বুঝতে কালচার অ্যান্ড সেন্সিটিভিটি পরীক্ষা করানো হয়।
এ ব্যাপারে মি. আহমেদ বলেন, রোগীর রোগের ধরণ বুঝে এক বা একাধিক নমুনা সংগ্রহ করা হয়। সাধারণত, রোগীর রক্ত, প্রস্রাব, কফ, লালা না হলে পুঁজ থেকে নমুনা সংগ্রহ করা হয়ে থাকে। সাধারণত জ্বর বা টাইফয়েডের লক্ষণ দেখা দিয়ে রক্ত পরীক্ষা করা হয়, ইউরিন ইনফেকশন, কিডনি জটিলতা হলে প্রস্রাবের নমুনা, ফুসফুস জনিত রোগ হলে লালা বা কফ আবার শরীরের কোথাও ফোঁড়া হলে- সেখান থেকে পুঁজের নমুনা নিয়ে পরীক্ষা করা হয় বলে জাননা মি. আহমেদ।
ল্যাবে মাইক্রোবায়োলজিস্টরা সেই নমুনা পরীক্ষা-নিরীক্ষা করেন। সেখানকার ব্যাকটেরিয়ার উপর বিভিন্ন প্রকার অ্যান্টিবায়োটিক দিয়ে দেখা হয় যে, সেই অ্যান্টিবায়োটিক ব্যাকটেরিয়াগুলোকে মেরে ফেলতে কিংবা এর বংশবিস্তার আটকাতে সক্ষম কি না।
এজন্য ল্যাবে গোলাকার চাকতি বা পেট্রি ডিশের ওপর ওই ব্যাকটেরিয়ার নমুনা কিছু দূর পর পর নেয়া হয়। সেই নমুনাগুলোর মাঝখানে ব্যাকটেরিয়ার কিছু খাবার বা কালচার মিডিয়াম দেয়া হয় যেন ব্যাকটেরিয়াগুলো দ্রুত বেড়ে ওঠে।
এরপর বেড়ে ওঠা ব্যাকটেরিয়ার একেকটির ভাগের ওপর একেক ধরণের অ্যান্টিবায়োটিক দেয়া হয়। তখন যদি দেখা যায় অ্যান্টিবায়োটিকের প্রভাবে ব্যাকটেরিয়া মারা যাচ্ছে বা বৃদ্ধি বন্ধ হয়ে যাচ্ছে তাহলে সেই ওষুধের পাশে লেখা হয় ইংরেজি অক্ষর ‘এস’ বা সেনসিটিভ।
যদি ব্যাকটেরিয়া মারতে না পারে তখন লেখা হয় ইংরেজি অক্ষর ‘আর’ বা রেসিস্টান্ট অর্থাৎ এই অ্যান্টিবায়োটিকটি ব্যাকটেরিয়া মারতে সক্ষম নয়। এটি ব্যাকটেরিয়া প্রতিরোধী। আবার ব্যাকটেরিয়াগুলোর বৃদ্ধি কমে গেলে লেখা হবে “আই” বা ‘ইন্টারমিডিয়েট’। অর্থাৎ এই ওষুধটি বেশি ডোজে কাজ করতে পারে।
ছবির উৎস, Getty Images
নমুনা দেয়ার পর রিপোর্ট হাতে পেতে ৭২ ঘণ্টার মতো সময় লাগতে পারে। সেই রিপোর্টের ফলাফলের প্রেক্ষিতে চিকিৎসক সিদ্ধান্ত নিয়ে থাকেন রোগীকে কোন অ্যান্টিবায়োটিক কেমন মাত্রায় দিতে হবে।
মি. আহমেদ তার ক্যারিয়ারে এমন অনেক রিপোর্ট হাতে পেয়েছেন যেখানে একজন রোগী ২০/২৫টি অ্যান্টিবায়োটিক রেসিস্ট্যান্ট অর্থাৎ কোন অ্যান্টিবায়োটিক কোনটি কাজ করবে না। বা সাধারণ রোগের ক্ষেত্রেও শুধুমাত্র হাই পাওয়ারের ওষুধ কাজ করছে। তবে কোন রোগী যদি আগেই অ্যান্টিবায়োটিক খেয়ে ফেলেন তাহলে ব্যাকটেরিয়া বিশেষ পদ্ধতিতে আইসোলেট করে পরীক্ষা করা হয় বলে জানান তিনি।








